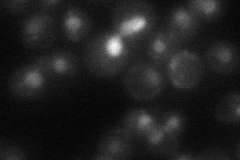
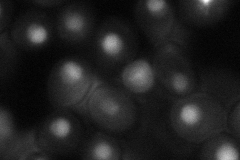

View description
Essential type II topoisomerase, relieves torsional strain in DNA by cleaving and re-sealing the phosphodiester backbone of both positively and negatively supercoiled DNA; cleaves complementary strands; localizes to axial cores in meiosis
Localization:
Intensity:
Fold change:
Significance:
-
C’ GFP library in SD

nucleus42.07 -
N' NOP1pr-GFP in SD

nucleus167.063 -
N' TEF2pr-mCherry in SD

nucleus203.15 -
N' NATIVEpr-GFP in SD
nucleus28.165 -
N' TEF2pr-VC and Cyto-VN in SD
nucleus,nucleolus61.8875 -
C’ GFP library in SD+DTT

nucleus29.920.71No -
C’ GFP library in SD+H2O2

nucleus38.590.91No -
C’ GFP library in Starvation Media

nucleus22.880.54Yes -
C’ GFP library on the background of Pup2-DaMP

nucleus -
C’ GFP library on the background of CCT mutant

nucleus36.91960.877434No
